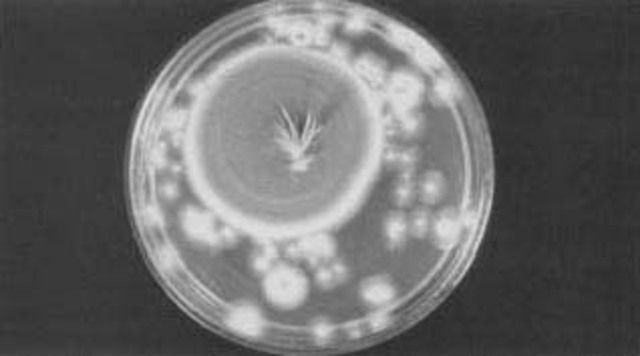
Discovery of Penicillin

-
-
impact that penicillin had upon medicine was profound as once devastating bacterial diseases could now be fought off with the new advent of antibiotics.
-
The United States and all of the countries who felt the ripple effects (which were many) learned just how important economic health was. The United States had impacted so much.
-
Start of Cold War
-
Man-made destructive power like the world had never before known and hardly dared to imagine was suddenly thrust upon us at the end of the Second World War. Nuclear and atomic energy was no longer a theory; it was a weapon, and a weapon that had now actually been used in combat. Nuclear weapons were brought upon, like in the cold war.
-
US Economic recovery for war town Europe, $13 Billion US loans.
-
Soviets blocked entrances to Berlin, allies cannot give supplies to West Berlin
-
US and British airplanes fly supplies into West Berlin.
-
USA and USSR compete in building Nuclear Weapons. USSR launched first Atomic Bomb in 1949.
-
UN forces were sent in to stop Communist aggression and expansion. The USSR supplied material to North Korea.
-
March 5, 1953 Moscow, Russia. Big impact in the war.
-
Vietnam Divided, turning them into separate districts, basing off of what side.
-
USA participated in the space race.
-
U-2 American Spy Plane shot down by USSR.
-
1941, Yuri Gagarin was just seven years old when the Nazis invaded the Soviet Union. They won the space race.
-
President Kenned gave orders for Bay of Pigs invasion, it failed.
-
Was built to keep east Germans from fleeing to West Germany.
-
Cuban missiles in exchange for the U.S. promising not to invade Cuba.
-
Intermediate Range Of Nuclear Forces, USA and USSR use this to rid the people and things of nuclear weapons
-
The Soviet Union had fallen of December of 1991. It fell, USA wins.
A list shows items. A timeline shows sequence.
Use Timetoast to make dates, milestones, and turning points easier to understand in a clear visual format. Timetoast is a timeline maker for work, school, research, and stories.